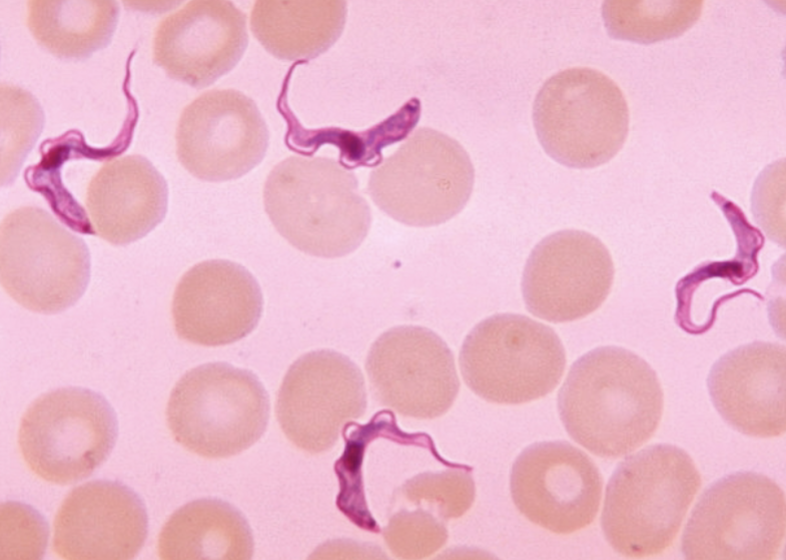
<p>What protist is this?</p>
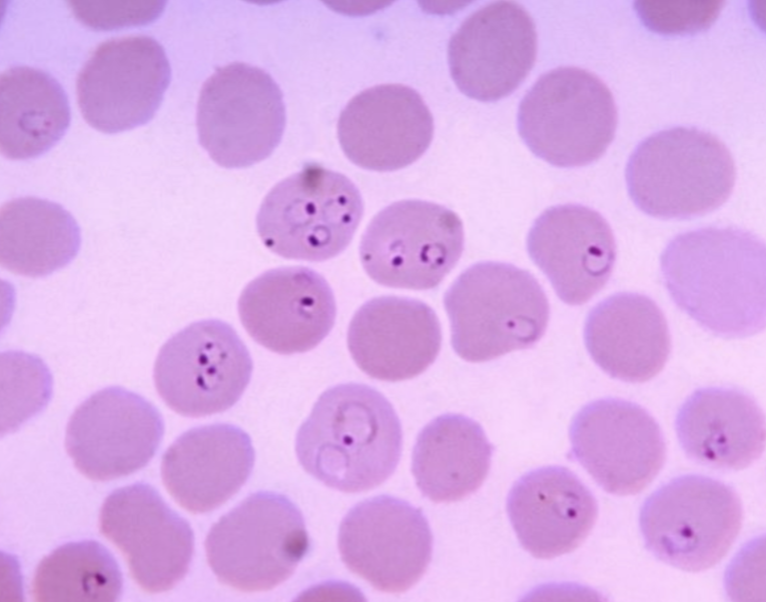
<p>What protist is this?</p>

1/65
Looks like no tags are added yet.
Name | Mastery | Learn | Test | Matching | Spaced | Call with Kai |
|---|
No analytics yet
Send a link to your students to track their progress

Giardia Trophozoite

cyst

Trypanosoma

Trichomonas

Entameba (cyst)

plasmodium

Balantidium Trophozoite

Leishmania

Larval Tapeworm Cysticercus Stage

Tapeworm Proglottids

Echinococcus (Adult)

Trichinella

Schistosoma (Male + Female worms together “in copula”)

Necator

adult fluke

Larval Fluke Metacercariae stage

Larval Fluke Cercaria stage

Larval Fluke Redia Stage

What helminth/fluke/parasitic worm is this?
Fasciola hepatica egg

What helminth/fluke/parasitic worm is this?
Fasciola hepatica miracidium larva

What helminth/fluke/parasitic worm is this?
Fasciola hepatica miracidium larva

What helminth/fluke/parasitic worm is this?
Fasciola hepatica redia larva

What helminth/fluke/parasitic worm is this?
Fasciola hepatica cercaria larva

What helminth/fluke/parasitic worm is this?
Fasciola hepatica cercaria larva

What helminth/fluke/parasitic worm is this?
Fasciola hepatica metacercaria larva

What helminth/fluke/parasitic worm is this?
Fasciola hepatica metacercaria larva

What helminth/fluke/parasitic worm is this?
Fasciola hepatica adult (unstained)

What helminth/fluke/parasitic worm is this?
Fasciola hepatica adult (stained)

What helminth/fluke/parasitic worm is this?
Fasciola hepatica (adult, stained)

What helminth/fluke/parasitic worm is this?
Schistosoma mansoni adults (male and female)

What cestode/tapeworm/parasitic worm is this?
Tapeworm eggs

What cestode/tapeworm/parasitic worm is this?
Taenia pisiformis cysticercus

What cestode/tapeworm/parasitic worm is this?
Taenia pisiformis cysticercus

What cestode/tapeworm/parasitic worm is this?
Taenia pisiformis

What cestode/tapeworm/parasitic worm is this?
Taenia pisiformis mature (upper) and gravid (lower)
(proglottids)

What cestode/tapeworm/parasitic worm is this?
Echinococcus granulosus adult

What cestode/tapeworm/parasitic worm is this?
Echinococcus granulosus adult

What nematode/roundworm/parasitic worm is this?
Enterobius vermicularis

What nematode/roundworm/parasitic worm is this?
Necator americanus

What nematode/roundworm/parasitic worm mouth is this?
Enterobius mouth

What nematode/roundworm/parasitic worm mouth is this?
Necator mouth

What nematode/roundworm/parasitic worm is this?
Trichinella spiralis

What protist is this?
Euglena

What protist is this?
Paramecium

What protist is this?
Amoeba

What protist is this?
Amoeba

What protist is this?
Amoeba

What protist is this?
Leishmania

What protist is this?
Leishmania

Whats this protist?
Leishmania
What protist is this?
trypanosoma

What protist is this?
Trypanosoma

What protist is this?
trypanosoma

What protist is this?
trichomonas

What protist is this?
trichomonas

What protist/cyst is this?
Giardia cyst

What protist/cyst is this?
Giardia cyst

What protist is this?
Giardia trophozoite

What protist is this?
Giardia trophozoite

What protist is this?
Giardia trophozoite

What protist/cyst is this?
Entameba cyst

What protist/cyst is this?
Entameba cyst

What protist/cyst is this?
entameba cyst

What protist is this?
Balantidium trophozoite

What protist is this?
Balantidium trophozoite
What protist is this?
Plasmodium falciparum